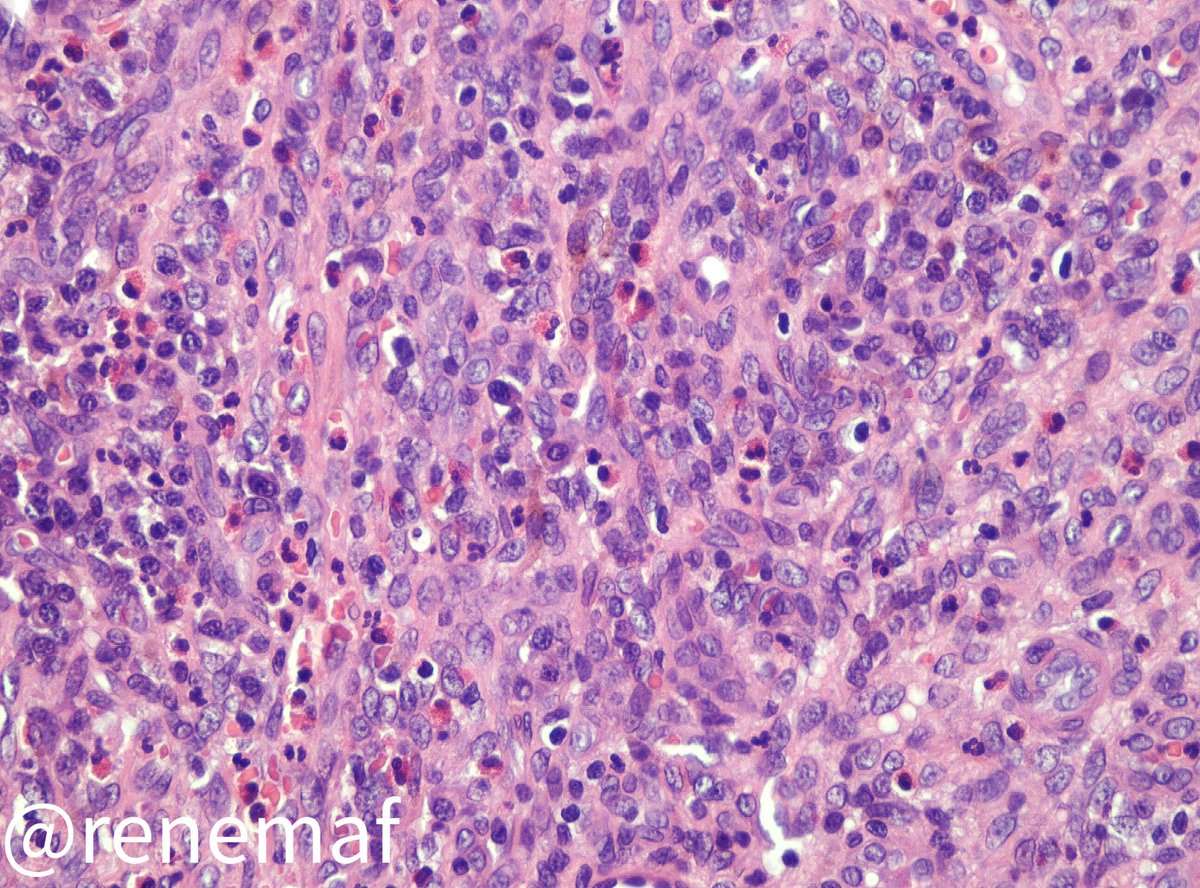
René Martínez Flores tweet media

obia retweetledi
obia
10 posts

obia retweetledi

⏰Deadline extension!
We have now extended the deadline for submitting to this cutting edge collection to March 2022.
Secure your place to submit today: fro.ntiers.in/21632
Frontiers - Oral Health@FrontOralHealth
📢Call for papers: #Salivary Gland #Tumors: Epidemiology, Pathology, Molecular Genetics, Management and Future Directions - hosted by Ibrahim Bello, Jean Santos and Fernanda Viviane Mariano. ➡️Register your submission today: fro.ntiers.in/21632
English
obia retweetledi

Spot diagnosis ! Male in 40's, radiolucent anterior maxillary( jaw) swelling. @DrNishatAfroz2 @nusrat_xahra @nucleololailo @PoloniaAntonio @asifwahab2012 @DrFahadAlam @premcharles #PathTwitter #oralpath #pathology




English
obia retweetledi

Register your participation in the Issue 'AI Applications in Oral Cancer and Oral Potentially Malignant Disorders'
Led by Alhadi Almangush (@helsinkiuni), Ibrahim Bello and Mohammed Elmusrati (@univaasa).
▶️fro.ntiers.in/AIOC
#AI#ArtificialIntelligence#OralCancer

English

#ThrowbackThursday to a couple weeks ago. This time it’s vulvar biopsy of a lesion from a young female in her 20’s, on chronic immunosupression for a kidney transplant. What is the infectious agent? #dermpath #gynpath #pathology #microbiology


English

A 3 months in duration painful ulcer in a 58-yo female, without relevant medical history. An incisional biopsy was perfomed. What are you thinking ? Spot diagnosis? #oralpath #oralpathology🔬 #oralmed #oralmedicine 👀

English

Case 8:
Benign salivary gland neoplasm composed of oncocytic epithelial cells lining papillary, ductal and cystic structures within rich lymphoid stroma
Note: the double layer of oncocytic epithelial cells
pathpresenter.net/publicDisplay/…




English

Review of salivary gland neoplasms for the #pathboards
#HNpath
@DrGeeONE @DrAldehyde @NigarAKhurram @neuropathmk @ALBoothMD @JMGardnerMD @kriyer68 @md_1701 @PrashantBavi @TransCytosis @orrhiker @redsnapperpath @TheKarenPinto @raghupillappa
English






